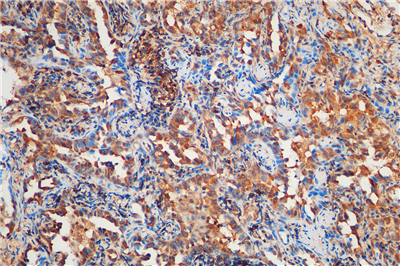

欢迎来到乐鱼网页版登录入口网站!

相关文章
Related Articles详细介绍
免疫组化是应用免疫学基本原理——抗原抗体反应,即抗原与抗体特异性结合的原理,通过化学反应使标记抗体的显色剂(荧光素、酶、金属离子、同位素) 显色来确定组织细胞内抗原(多肽和蛋白质),对其进行定位、定性及定量的研究,称为免疫组织化学技术(immunohistochemistry)或免疫细胞化学技术(immunocytochemistry)。
免疫组化的分类: 免疫组织化学技术按照标记物的种类可分为免疫荧光法、免疫酶法、免疫铁蛋白法、免疫金法等。
免疫组化主要步骤:
1.洗载玻片
2.包埋组织
3.切片
4.捞组织
5.脱蜡
6.抗原修复
7.血清封闭
8.加一抗
9.加二抗
10.加SABC
11.加显色剂
12.复染
13.脱水
14.封片
服务内容:包含抗体,包埋,切片,染色以及拍照。(每个样本提供一张照片包含阳性面积)加拍另外计费。
产品咨询